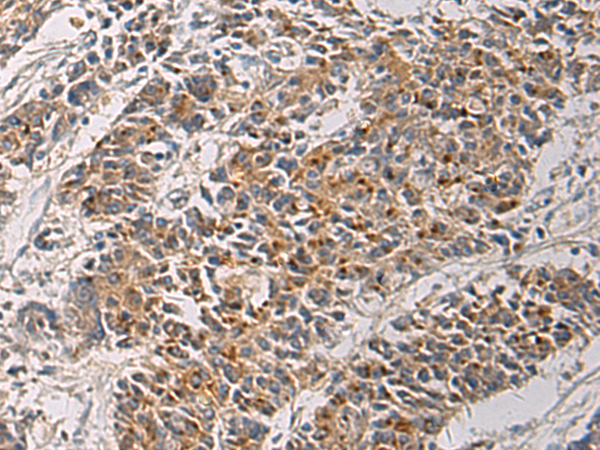

别名:3PK; MK-3; MDPT3; MAPKAP3; MAPKAP-K3; MAPKAPK-3应用:IHC
反应种属:Human, Mouse, Rat
规格:50μl/100μl
| Description |
|---|
| This gene encodes a member of the Ser/Thr protein kinase family. This kinase functions as a mitogen-activated protein kinase (MAP kinase)- activated protein kinase. MAP kinases are also known as extracellular signal-regulated kinases (ERKs), act as an integration point for multiple biochemical signals. This kinase was shown to be activated by growth inducers and stress stimulation of cells. In vitro studies demonstrated that ERK, p38 MAP kinase and Jun N-terminal kinase were all able to phosphorylate and activate this kinase, which suggested the role of this kinase as an integrative element of signaling in both mitogen and stress responses. This kinase was reported to interact with, phosphorylate and repress the activity of E47, which is a basic helix-loop-helix transcription factor known to be involved in the regulation of tissue-specific gene expression and cell differentiation. Alternate splicing results in multiple transcript variants that encode the same protein. |
| Specification | |
|---|---|
| Aliases | 3PK; MK-3; MDPT3; MAPKAP3; MAPKAP-K3; MAPKAPK-3 |
| Swissprot | Q16644 |
| Host/Isotype | Rabbit IgG |
| Storage | Store at 4°C short term. Aliquot and store at -20°C long term. Avoid freeze/thaw cycles. |
| Species Reactivity | Human, Mouse, Rat |
| Immunogen | Fusion protein of human MAPKAPK3 |
| Formulation | pH7.4 PBS, 0.05% NaN3, 40% Glycerol |
| Application | |
|---|---|
| IHC | 1/50-1/200 |
| ELISA | 1/5000-1/10000 |
![]() |
The image is immunohistochemistry of paraffin-embedded Human gastric cancer tissue using P03418(MAPKAPK3 Antibody) at dilution 1/60. (Original magnification: ×200) |
![]() |
The image is immunohistochemistry of paraffin-embedded Human colorectal cancer tissue using P03418(MAPKAPK3 Antibody) at dilution 1/60. (Original magnification: ×200) |
本公司的所有产品仅用于科学研究或者工业应用等非医疗目的,不可用于人类或动物的临床诊断或治疗,非药用,非食用。
暂无评论
本公司的所有产品仅用于科学研究或者工业应用等非医疗目的,不可用于人类或动物的临床诊断或治疗,非药用,非食用。
中文

发表回复